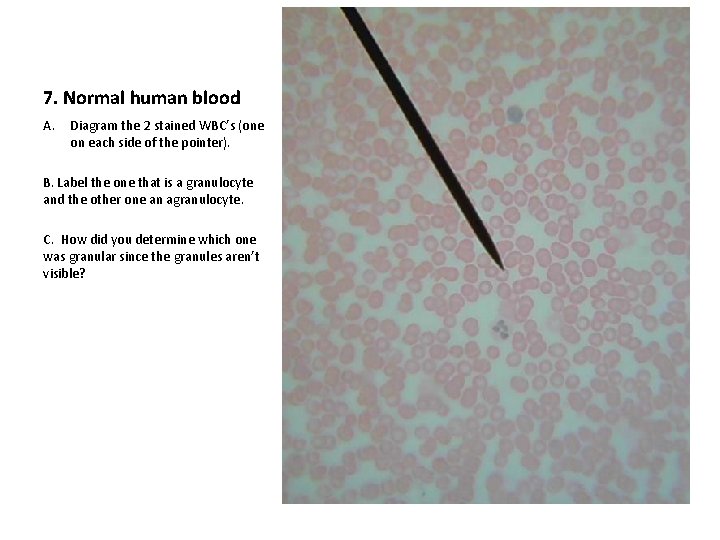
7. Normal human blood A. Diagram the 2 stained WBC’s (one on each side

Blood Lab Be sure and title the slide

Blood Lab *Be sure and title the slide on your paper and use colored pencils for your drawings

1. Normal human blood A. Diagram ONE of the RBC’s and ONE of the WBC’s. (Make them large enough to show detail) B. In this field, how many WBC’s are visible? C. Therefore, the approximate RBC number is _______.

2. Iron deficiency anemia A. Diagram B. Why are these erythrocytes paler than normal erythrocytes? C. How would that affect their ability to carry out their function? (book p. 218)

3. Song bird A. Diagram the blood of the smaller bird. B. Are the RBC’s nucleated? C. Are there any WBC’s visible? How could you tell?

4. Frog Blood A. Diagram the frog blood. B. Are the RBC’s nucleated? C. Is this the same as in human RBC’s?

5. Cow Blood A. Diagram a FEW of the cow’s blood cells large enough to show detail. B. What is different about their shape? C. What advantage might this shape provide?

6. Fish Blood A. Diagram the fish blood. B. Are these nucleated or nonnucleated RBC’s? C. Would these cells have to be made in the marrow?
7. Normal human blood A. Diagram the 2 stained WBC’s (one on each side of the pointer). B. Label the one that is a granulocyte and the other one an agranulocyte. C. How did you determine which one was granular since the granules aren’t visible?

8. Sickle Cell Anemia A. Diagram the blood of a sickle cell anemia patient. B. How have some of the RBC’s changed? C. Use the book to describe why people get sickle cell and what it causes? (p. 218)

9. Camel Blood A. Diagram the camel blood. B. Does the camel have both granular and agranular WBC’s? C. How can you tell?

10. Use the book p. 219 -220 A. What 2 leukocytes do phagocytosis? B. Which leukocyte produces antibodies? C. When having an allergic reaction, which 2 leukocytes may be produced in higher numbers?
- Slides: 11